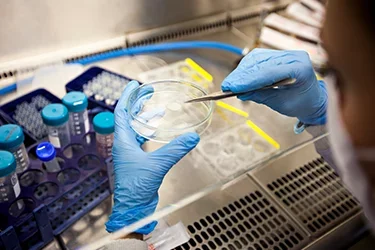
Neuroscience research

Neuroscience Research
Support UCLA Neuroscience
Learn MoreNeuroscience Researchers Are Developing Innovative Therapies To Treat Brain Diseases
UCLA is committed to a three-pronged approach to meet these demands. Devoting ourselves to healing humankind through outstanding patient care, fostering a cross-campus initiative for our neuroscience research community, and creating a unique environment dedicated to training great minds.
Patient Care

Healing humankind
UCLA Physicians are devoted to alleviating the pain and suffering of neurological and psychiatric disease by providing cutting edge treatments. They strive to create opportunities to engage with and improve the health of our neighbors.
Research
A cross-campus initiative
Neuroscience Research is dedicated to understanding the mysteries of how the brain develops and works, what goes wrong in brain diseases, and developing effective new therapies to treat diseases from brain tumors, depression and Alzheimer’s disease.
Education

A unique environment
UCLA Faculty, both physicians and researchers, are passionate about training the next generation of neuroscientists including undergraduate, graduate and medical students, as well as residents, postdoctoral and clinical fellows.
As a medical student, before you treat heart disease you learn about how the heart works. Before you treat kidney disease, you learn how the kidney works. The best therapies are based on an understanding of the biology of the system and the pathophysiology of the disease.
Simply put, if we are to manage and cure neuropsychiatric disease, we must learn how the brain works. Kelsey Martin, MD, PhD, a learning and memory researcher, has said.
A Complex Mystery
With perhaps tens of thousands of different types of brain cells, nearly 100 billion of them, and a 100 trillion connections between them, the human brain remains an extraordinary mystery. Remarkable progress in molecular biology, genetics, imaging technologies, and data analysis provides the neuroscience research team with exceptional tools to dig deeply into understanding how our brains work and what goes wrong when our brains do not function properly.
Understand, Then Cure.
Let’s dedicate ourselves to the type of fiercely open-minded scholarly inquiry that promises to uncover the causes of human disease. Learn more about what neuroscience research is being done, and the resources that can be found on campus, by disease.
Don't see what you are looking for? Try a filtered search.